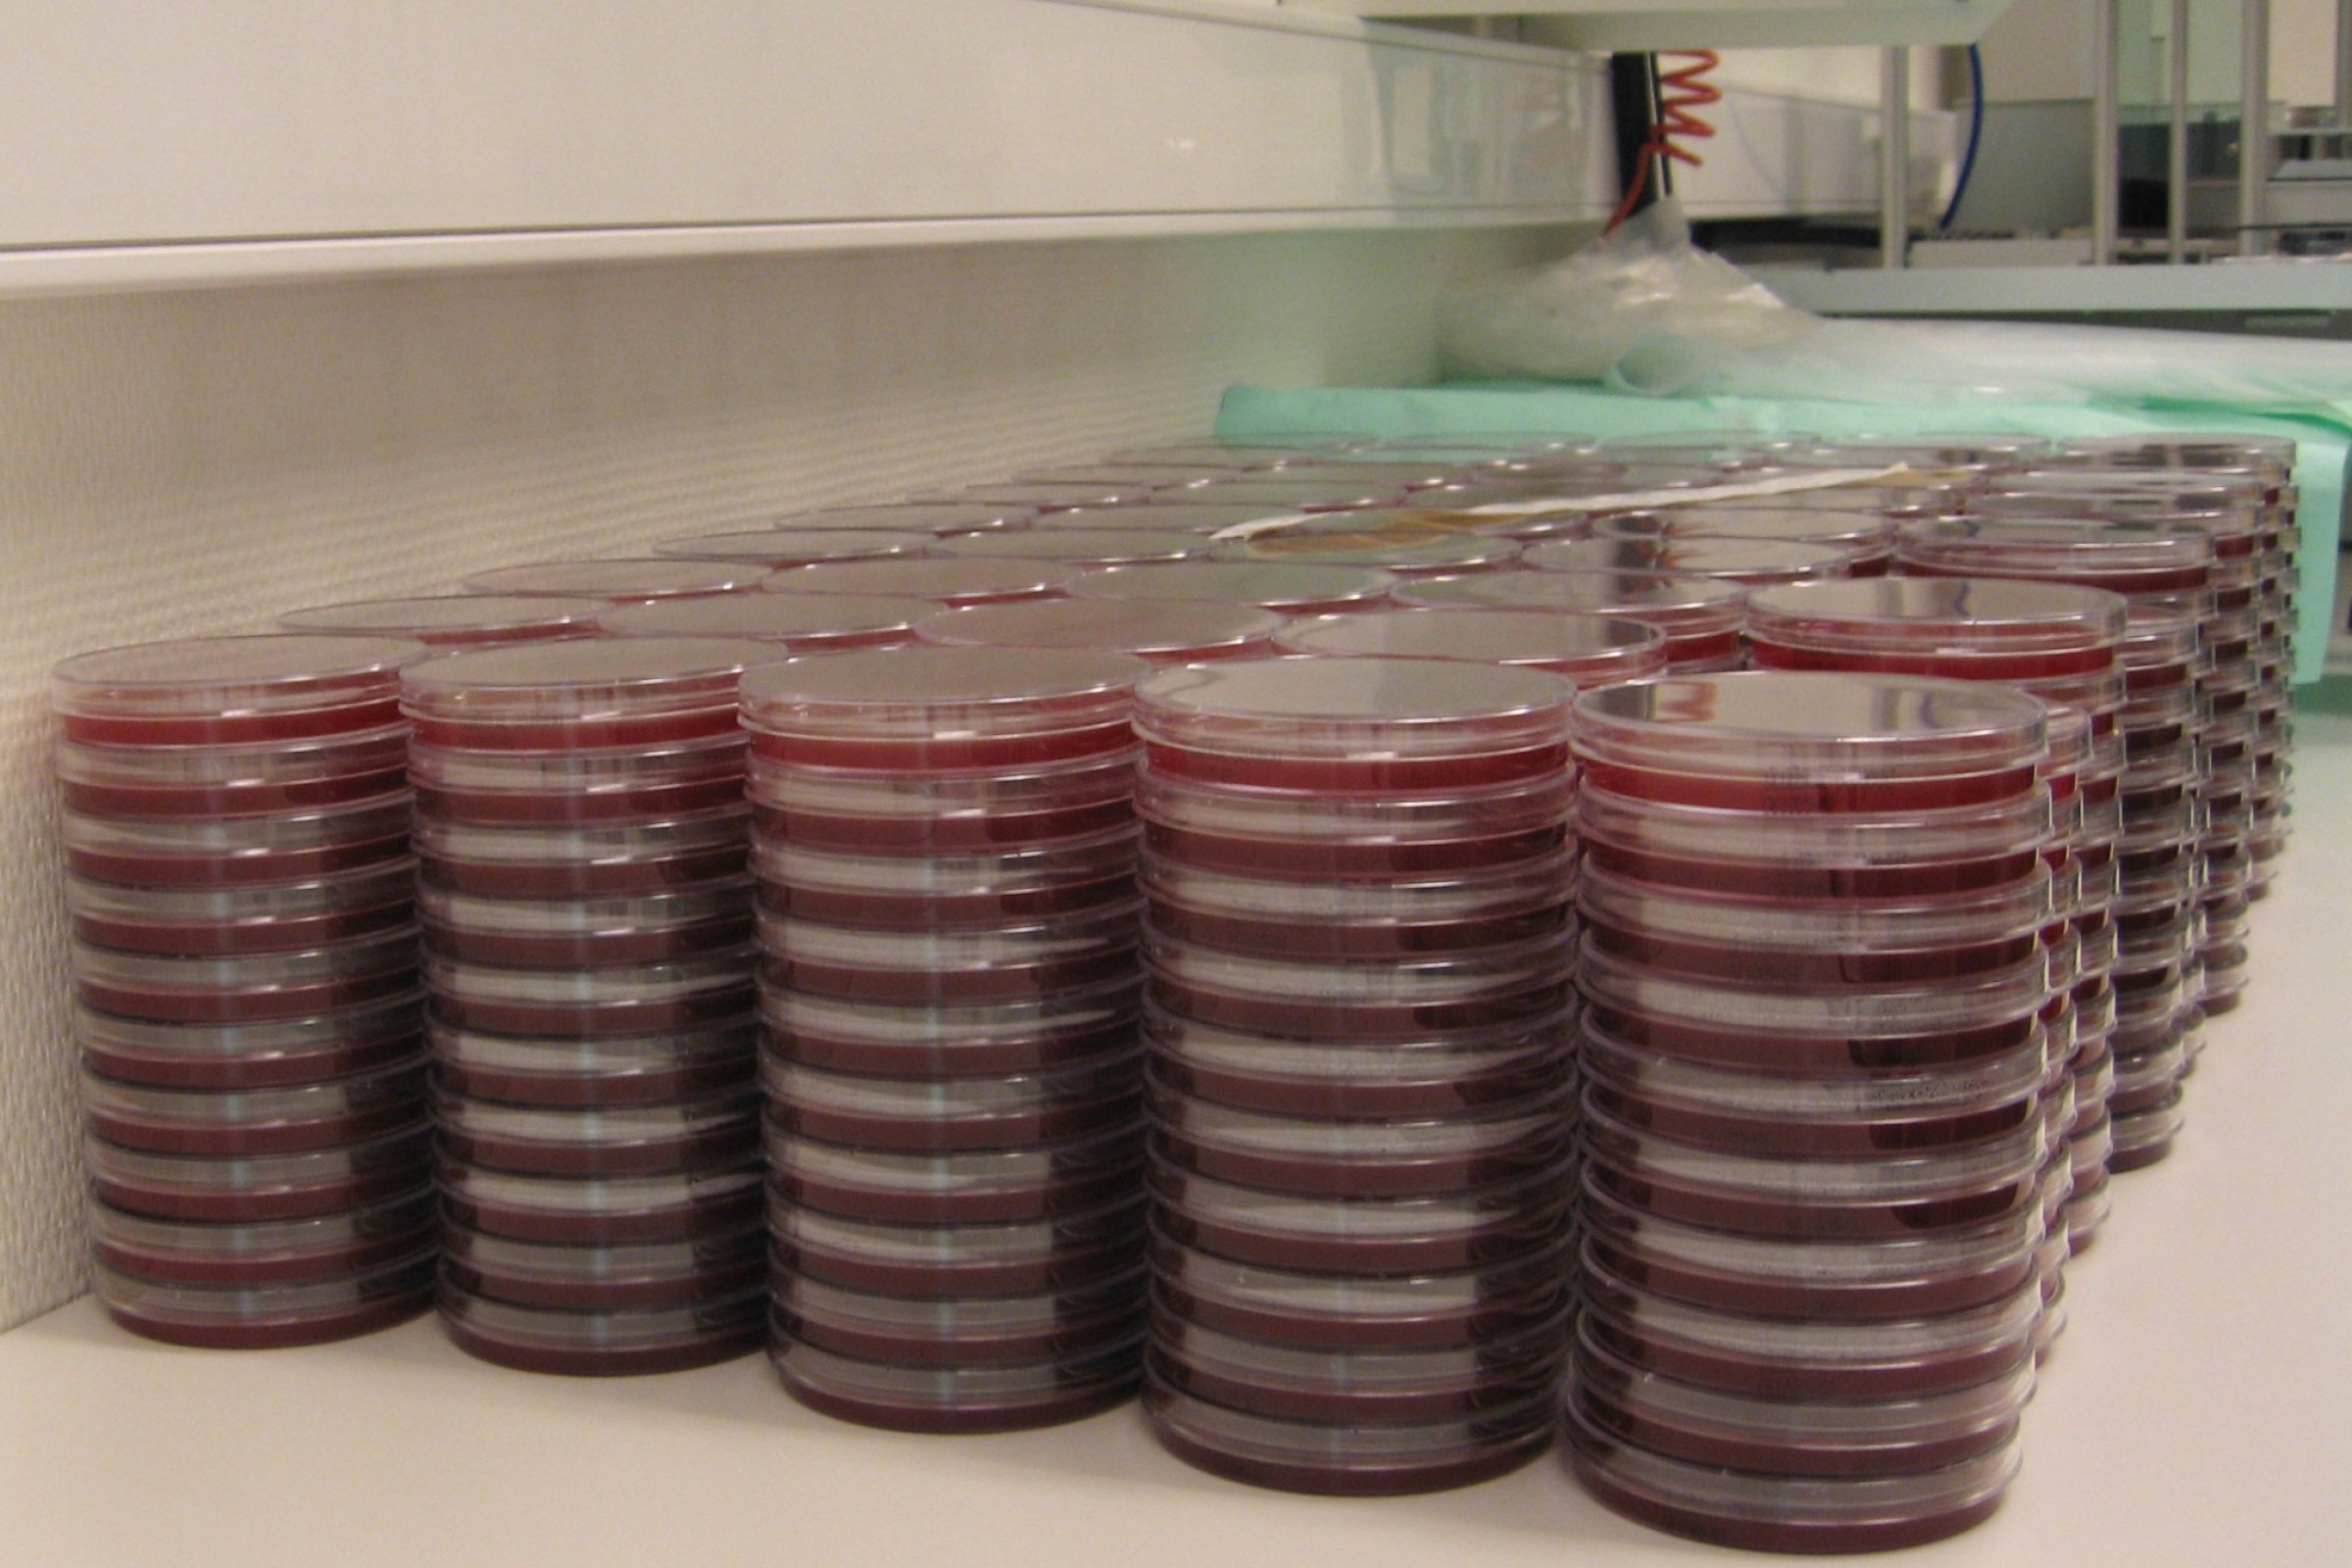

Medieproduksjon
Når vi dyrker mikroorganismer i laboratoriet brukes spesialtilpassede vekstmedier. Det er viktig at dissse er produsert med nøyaktighet og holder høy hygienisk kvalitet.
Vekstmedier brukes både til å dyrke frem mikroorganismer generelt, til å selektere slik at bare spesielle grupper vokser, og til å identifisere de ulike mikroorganismene.
Mikroorganismer er en meget heterogen gruppe som har svært varierende krav til nærings- og vekstbetingelser. Utgangspunktet for et dyrkningsmedium finner vi i den kjemiske sammensetningen av mikroorganismene.
De store variasjonene i mediene skyldes at ulike mikrooganismer har ulike krav til i hvilken form de kan oppta og utnytte de forskjellige næringstoffene og variasjonene kanskje størst når det gjelder karbon. Noen bakterier vokser godt i en uorganisk saltløsning med CO₂ som karbonkilde og lys som energikilde. Andre har så komplekse næringskrav at en fremdeles ikke har klart å dyrke dem på kunstige medier. Mellom disse ekstreme ytterpunktene finner en nær sagt alle varianter.
Hele 80 – 90 % av en celle består av vann som derved er det aller viktigste næringsstoffet. Av tørrstoffet i en celle utgjør makronæringsstoffene (C, H, O, N, P og S) ca. 96 % og metallene K, Na, Ca og Fe ca. 3 %. Resten kalles mikronæringsstoffer og de viktigste blant disse er metallene Mn, Co, Cu, Mo og Zn. Ethvert medium må altså dekke organismenes behov for alle disse næringsstoffene slik at cellene kan syntetisere de nødvendige cellekomponenter som proteiner, karbohydrater, fett, nukleinsyrer, celleveggkomponenter og andre biologiske molekyler.
De fleste trenger tilførsel av organiske forbindelser og en del bakterier – kanskje særlig patogene bakterier og andre som er tilpasset et liv i en kropp – har defekter i deler av syntesapparatet sitt, slik at de må tilføres vekstfaktorer som aminosyrer, vitaminer, purin- og pyrinidinbaser. Noen trenger også komplekst organisk materiale som hele blodceller.
Ulike typer vekstmedier
Variasjonene er altså mange og mediene er i tillegg sammensatt slik at vi på basis av vekst og andre karakteristika kan bruke dem til å identifisere de ulike mikroorganismene. En deler derfor mediene inn i grupper etter bruken:
Inneholder et rikt utvalg av næringsstoffer og hvor de fleste bakterier kan vokse
Inneholder stoffer som hemmer veksten av noen bakteriegrupper. Dette er viktige medier som muliggjør påvisning av bakterier som det finnes få av i prøven. Den selektive komponenten kan variere veldig. F.eks. brukes høy saltkonsentrasjon (NaCl) som selektiv komponent når vi leter etter stafylokokker. I andre tilfeller tilsettes antibiotika for å holde uønskete bakterier borte.
Inneholder substanser som gjør at det blir større forskjeller i utseende på ulike bakteriekolonier. Også her er variasjonene store. Eksempelvis kan blodskåler viser om en bakterie kan hemolysere blod, tilsetning av fargeindikator viser om bakteriene danner sure eller basiske nedbrytningsprodukter og kromogene komponenter i mediet gir karakteristisk farge på koloniene – alt opplysninger som hjelper oss til å identifisere de ulike bakteriene vi dyrker.
Kvalitetssikring av medieproduksjon
Uansett hva mediene inneholder er det viktig at produksjonen av dem er kvalitetssikret. Det er viktig med gode produksjonslokaler og en dyktig stab. Vann og andre råvarer må ha god kvalitet, utstyr som brukes rent, vekter og annet måleutstyr nøyaktig, og sterilisering av mediene må være nøye kontrollert. I tillegg må hver batch kontrolleres. Som et minimum må en gjøre en visuell kontroll av mediet for å sjekke at det har riktig farge og utseende forøvrig, man må sjekke pH og mediet må steriltestes dersom det ikke er sterilisert i utleveringsbeholderen. Der det er mulig må en også utføre en dyrkningskontroll for å se at mediet fungerer som forventet.
Veterinærinstituttets leverer høy kvalitet og spesialtilpassede medier
Vi produserer kvalitetssikret medier og reagenser til hele Veterinærinstituttet fra Sandnes i sør til Tromsø i nord. I tillegg har vi en lang rekke eksterne brukere. Vi leverer medier til skoler, universiteter og andre forskningsinstitusjoner og ikke minst til veterinærer innen ulike næringer både på sjø og på land.
Hovedtyngden av det vi produserer er standardmedier til diagnostikk av sykdom på fisk og landdyr og til mikrobiologisk kontroll av mat og fór.
Vår styrke er imidlertid å skreddersy og tilpasse medier til ulike forskningsprosjekter. Vi produserer det brukerne ønsker/trenger og har også erfaring fra utvikling av nye medier når det har vært nødvendig.